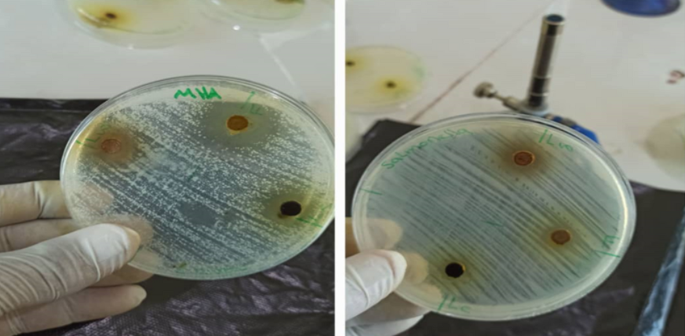
Fig. 1

Abstract
This study aimed to analyze the phytochemical constituents and evaluate the antimicrobial effects of ethanolic extracts from Matricaria chamomilla (chamomile) leaves and flowers against clinical bacterial isolates collected from Ibb City, Yemen. Phytochemical screening revealed presence of alkaloids, tannins, sterols, and terpenoids in both leaves and flowers, while flavonoids, glycosides, saponins, and amino acids were absent. Antibacterial activity was assessed using inhibition zone diameters against pathogens including Staphylococcus aureus, Escherichia coli, Salmonella spp., and Pseudomonas aeruginosa. The extracts showed significant antimicrobial activity, especially against S. aureus, with leaf extract showing a 24 mm inhibition zone and flower extract 15 mm. Minimum inhibitory concentration (MIC) and minimum bactericidal concentration (MBC) tests confirmed the potent bactericidal effects at low extract concentrations (100 mg/mL). These findings underscore the therapeutic potential of M. chamomilla as a natural antimicrobial agent relevant to combating bacterial infections, especially in the local Yemeni context. Further studies are recommended to isolate active compounds and evaluate mechanisms of action.
Introduction
Bacterial infections remain a major public health concern worldwide, exacerbated by rising antibiotic resistance that threatens effective treatment of infectious diseases (World Health Organization1. This growing concern has prompted a global search for novel therapeutic agents, particularly those derived from natural sources. Medicinal plants, which have been used for centuries in traditional healing systems, are now being re-examined through scientific lenses for their antimicrobial properties2.
A variety of medicinal and non-medicinal plant extracts have proven promising antimicrobial activity. For example, the essential oil of Foeniculum vulgare (fennel) showed significant inhibitory effects against pathogenic bacterial strains, highlighting its potential as a natural antibacterial agent. Essential oils from Rosmarinus officinalis (rosemary) and Lavandula officinalis (lavender) demonstrated substantial bacteriostatic activity, particularly against multidrug-resistant bacteria3,4. Agro-industrial byproducts such as olive mill wastewater (OMWW) from Fez-Boulman have also shown antimicrobial potential by effectively inhibiting several pathogenic bacteria5.
Likewise, essential oil of Origanum vulgare (oregano), extracted from the Ouazzane region of Morocco, showed broad-spectrum antimicrobial efficacy against resistant clinical isolates6. Furthermore, recent in vitro studies on Jatropha variegata (Euphorbiaceae) demonstrated strong antimicrobial effects against clinical isolates from Yemen, positioning this plant as a promising candidate for natural antimicrobial development7.
Matricaria chamomilla L. (German Chamomile), a well-known member of the Asteraceae family, is widely used in traditional medicine across Europe, Asia, and the Middle East. Its therapeutic applications range from treating gastrointestinal disturbances and skin inflammation to promoting relaxation and sleep. Chamomile is rich in pharmacologically active compounds such as flavonoids, terpenoids (notably α-bisabolol and chamazulene), and essential oils, which contribute to its diverse biological effects including antioxidant, anti-inflammatory, and antimicrobial activities8,9,10,11.
Several studies have highlighted the antimicrobial efficacy of M. chamomilla extracts and essential oils against a variety of Gram-positive and Gram-negative bacteria as well as fungi10,11. However, the extent of antimicrobial activity can vary significantly depending on factors such as the plant part used, geographic origin, extraction method, and concentration. Moreover, few studies have focused on comparing the antimicrobial potential of various parts of the chamomile plant against clinically relevant pathogens, especially in regions like Yemen where traditional medicine plays a significant role in healthcare.
Therefore, the current study was designed to assess the in vitro antibacterial activities of ethanolic extracts from the leaves and flowers of M. chamomilla collected from Ibb governorate, Yemen, against clinical isolates of Staphylococcus aureus, Escherichia coli, Salmonella spp., and Pseudomonas aeruginosa. Additionally, this study aimed to evaluate the phytochemical composition of the extracts and determine their minimum inhibitory concentrations (MIC) and minimum bactericidal concentrations (MBC).
Materials and methods
Plant collection and authentication
Leaves and flowers of Matricaria chamomilla were collected from the Assabal region, Ibb Governorate, Yemen, on 7 November 2022. The taxonomic identity of the plant was verified by Dr. Essam Aqlan (ORCID: 0000-003-3081-6361), Assistant Professor of Plant Taxonomy and Flora, Department of Biology, Faculty of Science, Ibb University. A voucher specimen (code JV202210/2) was deposited in the Herbarium of the Faculty of Medical Sciences, Al-Jazeera University.
After collecting, the plant materials were carefully washed, air-dried in the shade at room temperature for about four weeks, and then ground into a fine powder for extraction. The procedures for cleaning, shade-drying, and powdering the plant materials prior to extraction followed the methods described in our previous study.
With minor modifications7. The plant material used in this study was collected and used following all relevant institutional, national, and international guidelines and legislation.
Preparation of ethanolic extracts
Ethanolic extraction was performed following the protocol reported in our previous study12, with adjustments. Briefly, 95 g of powdered leaves and 95 g of powdered flowers were separately immersed in 450 mL of 96% ethanol and shaken intermittently for 72 h. After filtration, the plant residues were re-macerated under the same conditions. The combined filtrates were evaporated at 40 °C in a hot-air oven, and the dried extracts were preserved in amber bottles at room temperature until use.
Phytochemical screening
Qualitative phytochemical screening was conducted using standard protocols13, adapted from our earlier work7. The extracts were examined for the presence of secondary metabolites including alkaloids, glycosides, phenolics, flavonoids, tannins, terpenoids, saponins, carbohydrates, and proteins14,15,16.
Clinical bacterial isolates
Clinical isolates were obtained from routine diagnostic laboratories and subsequently re-identified using conventional microbiological procedures, as outlined previously7. The identified strains included Staphylococcus aureus, Escherichia coli, Salmonella spp., and Pseudomonas aeruginosa. Confirmation was achieved through Gram staining, microscopic examination, and biochemical assays in accordance with Bergey’s Manual of Determinative Bacteriology17.
Antimicrobial activity assay
The antimicrobial potential of the ethanolic extracts was evaluated using the agar well diffusion technique, adapted from our earlier study7.
-
Culture media and Inocula:
Mueller–Hinton agar (MHA) was used for bacterial cultures. Bacterial suspensions were standardized to the 0.5 McFarland turbidity standard (~ 1.5 × 10⁸ CFU/mL).
-
Extract solutions:
Stock solutions were prepared by dissolving 0.5 g of each crude extract in 1 mL of 10% dimethyl sulfoxide (DMSO).
-
Well diffusion assay:
Wells of 6 mm were created in MHA plates and filled with 50 µL of extract solution. Plates were incubated at 37 °C for 18–24 h, and inhibition zones were measured in millimeters.
Minimum inhibitory concentration (MIC) and minimum bactericidal concentration (MBC)
MIC and MBC were determined according to Clinical and Laboratory Standards Institute (CLSI) guidelines18.
-
MIC determination:
Serial dilutions (500–100 mg/mL) of the extracts were prepared in 10% DMSO. Each dilution (1.5 mL) was mixed with 13.5 mL of molten MHA at 55 °C, poured into Petri dishes, and inoculated with 2 µL of bacterial suspension (~ 2 × 105 CFU/spot). Plates having only DMSO served as negative controls. MIC was defined as the lowest extract concentration that completely inhibited visible growth after incubation at 37 °C for 24 h.
-
MBC determination:
Aliquots from MIC plates showing no visible growth were streaked onto fresh MHA and incubated for 24 h at 37 °C. The lowest concentration that yielded no bacterial colonies was taken as the MBC, representing ≥ 99.9% killing of the initial inoculum.
Results
Extract yield
The extract yield percentage was calculated using the following formula:
Based on this calculation, the ethanolic extracts of Matricaria chamomilla yielded 12.6% from leaves and 7.85% from flowers (Table 1). These yields reflect the efficiency of ethanol in extracting bioactive compounds from various parts of the plant.
Phytochemical composition
Phytochemical screening showed that both the leaves and flowers had important levels of tannins, alkaloids, sterols, and terpenoids. No flavonoids, glycosides, saponins, or amino acids were detected in either extract (Table 2).
Antimicrobial activity
The ethanolic extracts of Matricaria chamomilla displayed selective antimicrobial activity against the tested microorganisms (Table 3). The leaf extract showed the highest inhibition zone against Staphylococcus aureus (24 mm), significantly exceeding that of the flower extract (15 mm), with a mean value of 19.5 mm (SD = ± 6.36 mm). In contrast, the flower extract was more active against Escherichia coli (17 mm), while the leaf extract showed no measurable inhibition observed under the tested conditions (0 mm), resulting in the widest variation among the tested organisms (mean = 8.5 mm; SD = ± 12.02 mm). Both extracts produced equal inhibition zones against Salmonella spp. (15 mm), showing no variation (SD = 0). For Pseudomonas aeruginosa, the leaf extract demonstrated moderate activity (15 mm), while the flower extract was inactive, yielding a mean of 7.5 mm (SD = ± 10.61 mm).
Overall, the results show that the antimicrobial activity of M. chamomilla extracts is both organism- and extract-type dependent, with statistically notable differences in mean inhibition zones and standard deviations, especially for E. coli and P. aeruginosa. (Fig. 1; Table 3)
Antimicrobial activity of ethanolic extracts of Matricaria chamomilla leaves and flowers against clinical bacterial isolates.
Comparison with antibiotics
The ethanolic extracts of Matricaria chamomilla displayed selective antimicrobial activity against the tested microorganisms (Table 3). The leaf extract showed the highest inhibition zone against Staphylococcus aureus (24 mm), significantly greater than the flower extract (15 mm), with a mean inhibition zone of 19.5 mm (SD = ± 6.36 mm). In contrast, the flower extract was more active against Escherichia coli (17 mm), while the leaf extract showed no measurable inhibition observed under the tested conditions (0 mm), yielding the highest variability among tested organisms (mean = 8.5 mm; SD = ± 12.02 mm). Both extracts produced equal inhibition zones against Salmonella spp. (15 mm) with no variation (SD = 0). For Pseudomonas aeruginosa, the leaf extract demonstrated moderate activity (15 mm), while the flower extract was inactive, resulting in a mean of 7.5 mm (SD = ± 10.61 mm). These results show that antimicrobial activity is both organism- and extract-type dependent, with statistically notable differences in inhibition profiles, particularly for E. coli and P. aeruginosa.
When compared with standard antibiotics, M. chamomilla extracts showed lower antimicrobial activity, though with some notable exceptions (Table 3). Against S. aureus, the leaf extract (24 mm) was comparable to Gentamicin, Amoxicillin, and Cotrimoxazole (24 mm each), and close to Levofloxacin (28 mm) and Azithromycin (28 mm). The flower extract (15 mm) was markedly less effective than all antibiotics. For E. coli, the flower extract (17 mm) showed moderate inhibition but remained well below the activity of all antibiotics evaluated, particularly Ciprofloxacin (40 mm), while the leaf extract showed no inhibition. Both extracts inhibited Salmonella spp. equally (15 mm), but this was inferior to all antibiotics (≥ 24 mm). Notably, for P. aeruginosa, the leaf extract (15 mm) kept moderate activity, surpassing several antibiotics where resistance was observed, and approaching the effect of Imipenem (14 mm), while the flower extract was inactive. These findings suggest that although M. chamomilla extracts do not match the potency of conventional antibiotics, the leaf extract demonstrates promising activity against S. aureus and P. aeruginosa, including strains showing antibiotic resistance. (Table 3; Fig. 2).
Antibiogram and antimicrobial activity of M. Chamomilla extracts leaves and flowers.
Determination of minimum inhibitory concentration (MIC) and minimum bactericidal concentration (MBC) of plant extract
As shown in Table 4, the M. chamomilla flower ethanolic extract showed the same MIC (100 mg/mL) against Staphylococcus aureus, Escherichia coli, and Salmonella spp. This shows that a concentration of 100 mg/mL was sufficient to inhibit the visible growth of all tested bacteria. The MBC values were also 100 mg/mL for all three bacteria, suggesting that the concentration required to kill the organisms was identical to the concentration needed to inhibit their growth. This 1:1 MIC/MBC ratio indicates strong bactericidal activity at the MIC level.
The MIC for the leaf ethanolic extract was also 100 mg/mL for S. aureus, P. aeruginosa, E. coli, and Salmonella spp. (Table 5). However, the MBC values differed for some organisms: P. aeruginosa required a higher concentration (200 mg/mL) to achieve a bactericidal effect, suggesting a bacteriostatic effect at 100 mg/mL and a bactericidal effect at 200 mg/mL. S. aureus, E. coli, and Salmonella spp. had an MBC equal to the MIC (100 mg/mL), showing bactericidal activity at the MIC concentration.
The results show that both flower and leaf extracts of Matricaria chamomilla exhibit significant antibacterial activity at low concentrations (100 mg/mL), effectively inhibiting the growth of a wide spectrum of bacterial species. The similarity of MIC and MBC values for most bacterial isolates suggests a strong bactericidal effect, especially against Staphylococcus aureus, Escherichia coli, and Salmonella spp. However, the higher MBC observed for Pseudomonas aeruginosa when treated with the leaf extract shows a slightly reduced bactericidal efficiency, which may be attributed to its inherent resistance mechanisms or unique cell envelope structure. MIC and MBC determinations were performed in triplicate, and identical results were obtained in all experiments.
Discussion
Matricaria chamomilla (chamomile) is a well-recognized medicinal plant belonging to the Asteraceae family, with over 120 chemical constituents contributing to its diverse biological activities. Numerous studies have demonstrated its antibacterial activity against both Gram-positive and Gram-negative bacteria, primarily attributed to bioactive compounds such as α-bisabolol, luteolin, quercetin, and apigenin, which also provide anti-inflammatory, antiviral, and antioxidant effects19. Importantly, this study provides the first MIC and MBC data for M. chamomilla collected in Yemen and evaluated against local clinical isolates from Ibb City. While MICs were higher than those reported by Alkuraishy et al. (2015) (2–8 mg/mL) and Mekonnen et al. (2016) (4–16 mg/mL) using standard strains or essential oils, the use of clinically relevant, potentially multidrug-resistant isolates explains the observed differences, highlighting the real-world applicability of our findings20,21. This approach strengthens the translational relevance of the findings and better reflects real-world antimicrobial resistance patterns in the local healthcare setting.
Previous research reported antibacterial effects of M. chamomilla extracts against Gram-negative strains including Escherichia coli, Pseudomonas aeruginosa, Klebsiella pneumoniae, and Enterobacter aerogenes, as well as Gram-positive strains like Staphylococcus aureus and Enterococcus faecalis, encompassing both methicillin-resistant and methicillin-susceptible isolates. However, the MICs in these studies were relatively high (> 1 mg/mL), indicating limited potency under those experimental conditions11.
In the present study, the extraction yields of M. chamomilla leaves and flowers were 12.6% and 7.85%, respectively, differing from previous reports such as 20.85% via 50% ethanol maceration and 4.60% via Soxhlet extraction of unprocessed flowers22, These variations likely reflect differences in geographic origin, environmental conditions, and extraction methodologies, which also influence the concentration and composition of bioactive phytochemicals and, consequently, antibacterial activity. Importantly, higher yields do not necessarily correlate with greater potency if key antimicrobial constituents are present in low proportions or altered by extraction conditions.
Phytochemical screening revealed elevated levels of tannins, sterols, terpenoids, and alkaloids in both leaves and flowers, whereas saponins, amino acids, flavonoids, and glycosides were absent. These findings partially align with methanolic extract analysis23, and chromatographic studies24 highlighting the impact of extraction method and plant organ on phytochemical composition. The bioactive compounds exert antibacterial effects through multiple mechanisms, including disruption of the bacterial cell structure leading to increased membrane permeability and leakage of intracellular contents, modification of the cell wall and membrane integrity, depletion of cellular ATP, inhibition of protein synthesis, damage to intracellular components, disturbances in intracellular pH, DNA fragmentation, and interference with bacterial quorum sensing25,26,27,28.
The absence of flavonoids likely represents the predominant factor underlying the weak susceptibility of P. aeruginosa to the extracts, as these compounds constitute the primary bioactive agents exhibiting potent antibacterial activity against this pathogen.
The ethanolic leaf extract demonstrated the highest activity against S. aureus, with moderate activity against E. coli and Salmonella species, showing inhibition zones of 27 mm and 18 mm, respectively, at 400 µg/mL11.MIC and MBC values for the flower extract were 100 mg/mL against S. aureus, E. coli, and Salmonella, consistent with other studies reporting MICs of 12.5–50 mg/mL depending on strain and assay method29.
Beyond antimicrobial effects, M. chamomilla has demonstrated wound-healing potential, improving linear incisional and burn wound repair in experimental animal models30,31. This supports the translational relevance of its bioactive compounds for both antimicrobial and regenerative applications. Notably, certain pathogens, including P. aeruginosa and E. faecalis, were resistant, suggesting strain-specific susceptibility influenced by the absence of flavonoids, low outer membrane permeability, and efflux systems32.
Comparative evaluation of leaf versus flower extracts served as an internal control. The higher antibacterial activity of leaves may be attributed to organ-specific differences in the abundance of bioactive constituents, consistent with previous observations in chamomile and other medicinal plants.
In summary, the antibacterial activity observed in this study is mechanistically linked to the phytochemical composition of the extracts, with terpenoids, tannins, and α-bisabolol playing key roles. The organ-specific variation between leaves and flowers, coupled with differences in resistance profiles among bacterial strains, underscores the importance of considering plant part selection and pathogen susceptibility in future investigations.
Limitation of the study
This study evaluated a limited number of pathogenic strains; thus, findings may not be generalizable across all clinically relevant microbes. Furthermore, in vitro antimicrobial activity does not necessarily translate directly to in vivo efficacy due to complex pharmacokinetic and pharmacodynamic factors influencing bioavailability and interaction with host tissues.
Conclusions
This study demonstrates that Matricaria chamomilla leaves and flowers contain significant bioactive compounds, including tannins, sterols, terpenoids, and alkaloids, which contribute to notable antibacterial activity, particularly against Staphylococcus aureus. Importantly, Pseudomonas aeruginosa, a multidrug-resistant strain, exhibited sensitivity to the extracts, highlighting their potential as alternative or adjunct antimicrobial agents. Variation in extraction yields and phytochemical profiles underscores the influence of geographic origin and extraction methodology.
Future directions include the isolation and detailed characterization of active compounds using GC–MS and LC-MS/MS, assessment of cytotoxicity, and exploration of potential synergistic effects with conventional antibiotics. Further research should also expand to a broader spectrum of pathogens, perform in vivo efficacy studies, evaluate safety and toxicity profiles, and investigate the underlying mechanisms of action to support the development of M. chamomilla-based antimicrobial therapies.
Data availability
All data generated and analyzed during this study are included in this published article.
Abbreviations
- M. chamomilla :
-
Matricaria chamomilla
- EOs:
-
Essential oils
- CFU:
-
Colony forming unit
- Azm15:
-
Azithromycin
- Gen:
-
Gentamicin
- Am:
-
Amphotericin
- CIP5:
-
Ciprofloxacin
- OF5:
-
Ofloxacin
- COT75:
-
Clotrimazole
- CFM5:
-
Cefexime
- LE5:
-
Levofloxacin
- NX10:
-
Nalidixic acid
- IPM10:
-
Impepem
- --:
-
Not applicable
- R:
-
Resistant
- MIC:
-
Minimum inhibitory concentration
- MBC:
-
Minimum bactericidal concentration
- P. aeruginosa :
-
Pseudomonas aeruginosa
- S. aureus :
-
Staphylococcus aureus
References
WHO. Antimicrobial resistance (2020).
Cowan, M. M. Plant products as antimicrobial agents. Clin. Microbiol. Rev. 12 (4), 564–582 (1999).
Barrahi, M. et al. Chemical composition and evaluation of antibacterial activity of fennel (Foeniculum vulgare Mill) seed essential oil against some pathogenic bacterial strains. Casp. J. Environ. Sci. 18 (4), 295–307 (2020).
Chahboun, N. et al. Evaluation of the bacteriostatic activity of the essential oil of Lavandula officinalis towards of the original strains resistant to antibiotics clinic. J. Mater. Environ. Sci. 6, 1186–1191 (2015).
Esmail, A. et al. Étude de l’activité antimicrobienne des margines issues de Fès Boulman vis-à-vis de souches pathogènes. Study of antimicrobial activity of Olive Mille wastewater (OMWW) from Fez Boulman against some pathogenic strains. J. Mater. Environ. Sci. 2015, 2028–2508 (2015).
Lakhrissi, B. et al. Extraction and evaluation of antibacterial activity of essential oils of oregano (Origanum vulgare) in the region of Ouazzane, Morocco. RRBS 10 (2), 57–61 (2015).
Esmail, A. et al. In-vitro antimicrobial activity of Jatropha variegata Vahl.(Euphorbiaceae) against some pathogenic microbes isolated from clinical samples in Ibb City, Yemen. Sci. Rep. 15 (1), 24409 (2025).
Das, S. et al. Antimicrobial activity of chamomile essential oil: effect of different formulations. Molecules 24, 23 (2019).
Catani, M. V., Rinaldi, F., Tullio, V., Gasperi, V. & Savini, I. Comparative analysis of phenolic composition of six commercially available chamomile (Matricaria chamomilla L.) extracts: potential biological implications. Int. J. Mol. Sci. 22 (19), 10601 (2021).
Al-Snafi, A. E. & Hasham, L. F. Bioactive constituents and pharmacological importance of Matricaria chamomilla: a recent review. GSC Biol. Pharm. Sci. 22, 079–98 (2023).
Sah, A. et al. A comprehensive study of therapeutic applications of chamomile. Pharmaceuticals 15 (10), 1284 (2022).
Dilbato Dinbiso, T. et al. Antimicrobial activity of selected ethnoveterinary medicinal plants of Southern region, Ethiopia. Infect. Drug Resist. 2022, 6225–6235 (2022).
Visweswari, G., Christopher, R. & Rajendra, W. Phytochemical screening of active secondary metabolites present in Withania somnifera root: role in traditional medicine. Int. J. Pharm. Sci. Res. 4 (7), 2770 (2013).
Raaman, N. Phytochemical Techniques (New India Publishing, 2006).
Evans, W. C. Trease and Evans’ Pharmacognosy (Elsevier Health Sciences, 2009).
Harborne, A. Phytochemical Methods a Guide To Modern Techniques of Plant Analysis (Springer Science & Business Media, 1998).
Whitman, W. B. et al. Bergey’s Manual of Systematics of Archaea and Bacteria (Wiley Online Library, 2015).
Humphries, R. M. et al. CLSI methods development and standardization working group best practices for evaluation of antimicrobial susceptibility tests. J. Clin. Microbiol. 56 (4), 01934–01917. https://doi.org/10.1128/jcm (2018).
Kameri, A., Haziri, A., Hashani, Z., Dragidella, A. & Kurteshi, K. AAntibacterial effect of Matricaria chamomilla L. extract against Enterococcus faecalis. Clin. Cosmet. Investig. Dentistry 15, 13–20 (2023).
Alkuraishy, H. M., Al-Gareeb, A. I., Albuhadilly, A. K. & Alwindy, S. In vitro assessment of the antibacterial activity of Matricaria chamomile alcoholic extract against pathogenic bacterial strains. Br. Microbiol. Res. J. 7 (2), 55–61 (2015).
Mekonnen, A., Yitayew, B., Tesema, A. & Taddese, S. In vitro antimicrobial activity of essential oil of thymus schimperi, Matricaria chamomilla, Eucalyptus globulus, and Rosmarinus officinalis. Int. J. Microbiol. 2016, 9545693 (2016).
Molnar, M., Mendešević, N., Šubarić, D., Banjari, I. & Jokić, S. Comparison of various techniques for the extraction of umbelliferone and herniarin in Matricaria chamomilla processing fractions. Chem. Cent. J. 11 (1), 78 (2017).
Khan, M. & Shamim, S. Understanding the mechanism of antimicrobial resistance and pathogenesis of Salmonella enterica serovar Typhi. Microorganisms 10 (10), 2006 (2022).
Ugi, B., Abeng, F., Obeten, M. & Uwah, I. Management of aqueous corrosion of federated mild steel (Local constructional steel) at elevated temperatures employing environmentally friendly inhibitors: Matricaria chamomilla plant. Management 3 (1), 6–12 (2019).
Cheesman, M. J., Ilanko, A., Blonk, B. & Cock, I. E. Developing new antimicrobial therapies: are synergistic combinations of plant Extracts/Compounds with conventional antibiotics the solution? Pharmacogn Rev. 11 (22), 57–72 (2017).
Gemeda, N. et al. Development, characterization, and evaluation of novel broad-spectrum antimicrobial topical formulations from Cymbopogon martini (Roxb.) W. Watson essential oil. Evid.-Based Complement. Altern. Med. 2018, 9812093 (2018).
Fazly Bazzaz, B. S. et al. Solid lipid nanoparticles carrying Eugenia Caryophyllata essential oil: the novel nanoparticulate systems with broad-spectrum antimicrobial activity. Lett. Appl. Microbiol. 66 (6), 506–513 (2018).
Fatemi, N., Sharifmoghadam, M. R., Bahreini, M., Khameneh, B. & Shadifar, H. Antibacterial and synergistic effects of herbal extracts in combination with Amikacin and Imipenem against Multidrug-Resistant isolates of acinetobacter. Curr. Microbiol. 77 (9), 1959–1967 (2020).
Alibabaei, Z., Rabiei, Z., Rahnama, S., Mokhtari, S. & Rafieian-kopaei, M. Matricaria chamomilla extract demonstrates antioxidant properties against elevated rat brain oxidative status induced by amnestic dose of scopolamine. Biomed. Aging Pathol. 4 (4), 355–360 (2014).
Jarrahi, M. An experimental study of the effects of Matricaria chamomilla extract on cutaneous burn wound healing in albino rats. Nat. Prod. Res. 22 (5), 422–427 (2008).
Jarrahi, M., Vafaei, A. A., Taherian, A. A., Miladi, H. & Rashidi Pour, A. Evaluation of topical Matricaria chamomilla extract activity on linear incisional wound healing in albino rats. Nat. Prod. Res. 24 (8), 697–702 (2010).
Breidenstein, E. B., de la Fuente-Núñez, C. & Hancock, R. E. Pseudomonas aeruginosa: all roads lead to resistance. Trends Microbiol. 19 (8), 419–426 (2011).
Acknowledgements
We express our sincere gratitude to Alfa Medical Labs and Arafaa Medical Labs. Ibb City, for providing the necessary strains of pathogenic bacteria to conduct this work, and also great thanks to the specialist doctors and staff in the Pharmacy Department of Al Jazeera University, for their assistance. We also would like to thank Dr. Essam Aqlan (ORCID: 0000-003-3081-6361), Assistant Professor of Plant Taxonomy and Flora, Department of Biology, Faculty of Science, Ibb University, for his assistance in the taxonomic identification of the plant material used in this study.
Funding
There is no participating funding.
Author information
Authors and Affiliations
Contributions
Abeer Esmail and Asmaa Hassan contributed to writing the manuscript and interpreting the data. Khadeja Almuntaser responsible of phytochemical analysis. Asmaa Hassan, Nasibh Alashari, Nosiubah Alkadry, Reem Alnahi, Ammar AL-Farga, Nadia Alhubaishy, Halah Alhagwa, Rehab Hamza and Tasneem Alnuzaili conceived the study. Abeer Esmail supervised the study. All authors have read and approved the definitive version of the manuscript.
Corresponding authors
Ethics declarations
Competing interests
The authors declare no competing interests.
Ethical approval
All authors have reviewed and approved the final manuscript and consented to its publication. More information Correspondence and requests for materials should be addressed to A.E.
Additional information
Publisher’s note
Springer Nature remains neutral with regard to jurisdictional claims in published maps and institutional affiliations.
Rights and permissions
Open Access This article is licensed under a Creative Commons Attribution 4.0 International License, which permits use, sharing, adaptation, distribution and reproduction in any medium or format, as long as you give appropriate credit to the original author(s) and the source, provide a link to the Creative Commons licence, and indicate if changes were made. The images or other third party material in this article are included in the article’s Creative Commons licence, unless indicated otherwise in a credit line to the material. If material is not included in the article’s Creative Commons licence and your intended use is not permitted by statutory regulation or exceeds the permitted use, you will need to obtain permission directly from the copyright holder. To view a copy of this licence, visit http://creativecommons.org/licenses/by/4.0/.
About this article
Cite this article
Esmail, A., Hassan, A., Almuntaser, K. et al. Phytochemical composition and antimicrobial activity of Matricaria chamomilla ethanolic extracts against clinical bacterial isolates in Ibb City, Yemen. Sci Rep 16, 7098 (2026). https://doi.org/10.1038/s41598-026-38001-z
Received:
Accepted:
Published:
Version of record:
DOI: https://doi.org/10.1038/s41598-026-38001-z